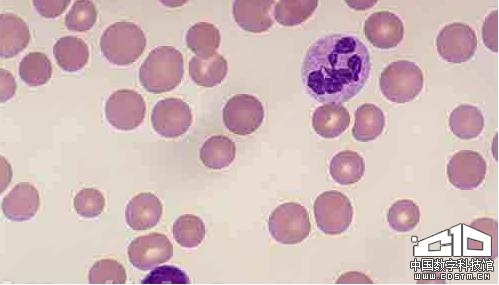

每日科学(12011年3月13日)——虽然现在普遍推荐孕妇在孕期补充铁剂,但除非是贫血,额外摄入过量的铁对孕妇没有明显好处。这是Tropical Medicine Antwerp学院的研究人员通过跟踪观察Burkina Faso一千多名孕妇得到的结果。
我们的身体需要铁来制造血红蛋白,在血红细胞中这种物质负责在我们体内运输氧气。在西方国家,贫血很少见,但在非洲多达半数的女性患贫血。在这项研究的1268名孕妇中,43%有贫血。
给这些妇女中的一半每天补充60毫克的铁剂药片 (加有叶酸),另一半每天补充30毫克铁剂药片(加有叶酸、锌、维生素A、C等微量元素)。人员分在哪组随机确定,持续服药3个月。在研究结束时,不管她们摄入剂量的多少,所有人血液中的铁含量基本位于同一水平。血红蛋白浓度大约为
在怀孕期间,不断成长的胎儿需要氧气,母亲自然需要比平时更多的铁,直至孕期结束。但是,额外补充铁并不能阻止她们的血红蛋白水平轻微地下降。 “为不贫血的女性补充铁是否有益还不明确。”作者在《美国临床营养学杂志》上说。
在非洲,许多人营养不良,生活环境中经常有寄生虫,许多的女性患有性贫血,这种情况下当然应该补充铁剂。对于患贫血的孕妇,补充铁剂可以使她们体内的铁元素水平提高到其他正常孕妇的水平,即略低于正常水平。
【本文由chuyuan独家授权中国数字科技馆使用,未经许可请勿转载。商业或非商业使用请联系中国数字科技馆】










京公网安备11010502039775号


